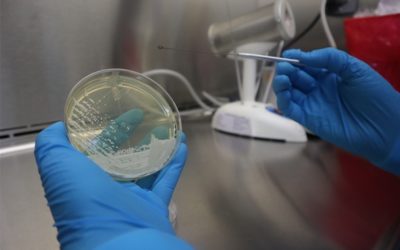
Ministerio de Salud alerta por hallazgo de nuevo hongo en Guatemala

Con información de Herberth Tax A solicitud del diputado César Fión de la UNE, el Congreso otorgó un minuto de silencio en memoria de la niña Sharon Figueroa, quien fue asesinada en Melchor de Mencos, Petén. https://twitter.com/stereo100xela/status/1359644819585454081...
Resultados de su búsqueda
5 mil hectáreas han sido afectadas por incendios forestales en el occidente de Guatemala
Con información de Edgar Domínguez Totonicapán. El Instituto Nacional de Bosques (INAB) región 6, informó que durante los últimos tres años han ocurrido al menos 300 incendios en la región occidente lo que ha provocado que unas 5 mil hectáreas de bosques tengan serios...
Proponen instalar el primer Museo Nacional del Bombero en Quetzaltenango
Por Moisés Cottom | Este miércoles, Raúl Izas, presidente de la Junta de Oficiales de Bomberos Voluntarios, explicó que han tenido acercamientos con las autoridades superiores para instalar el primer Museo Nacional del Bombero en Quetzaltenango. Izás dijo que hay...
En dos horas de operativos PMTQ sanciona a 62 motoristas y consigna nueve motocicletas
Con información de Raúl Juárez La Policía Municipal de Tránsito de Quetzaltenango (PMTQ) comenzó con operativos para la verificación de motoristas, como una campaña de sensibilización a los pilotos para el uso del caso. Edward Osorio, subjefe de la PMTQ, informó que...
Ministerio de Salud alerta por hallazgo de nuevo hongo en Guatemala
Por Shirlie Rodríguez | Este miércoles, el Ministerio de Salud Pública y Asistencia Social (MSPAS) informa a la población que el Laboratorio Nacional de Epidemiología emitió una alerta por el primer hallazgo de candida auris en Guatemala. Según la explicación...
Localizan cadáver de la niña Sharon Figueroa
Por Fernando Castellanos y Luis Hernández | Este miércoles, la historia de la búsqueda de Sharon Jasmine Figueroa Arriaza, de 8 años, tuvo un desenlace trágico. https://twitter.com/alba_keneth/status/1359330348728016898 El cadáver de la niña fue localizado, este...
Incendio fábrica de camas: «Se quedan muchos sueños acá, pero nos tenemos que levantar y resurgir de donde estamos»
Por Raúl Juárez | Unos 80 empleados de la empresa Industria AyG de Los Altos S.A., con lágrimas, lamentaron el incendio que esta madrugada acabó con media fábrica que se dedica a la producción de camas y distribución en los 22 departamentos de Guatemala. Desde la...
«Venite» inicia apoyo, con internet gratuito, a centros educativos en Quetzaltenango
Por Carlos González | La empresa «Venite» inicia este miércoles el proyecto para dotar de internet gratuito a escuelas de Quetzaltenango y Mazatenango, las cuales cuentan con equipo de cómputo. El proyecto comienza este día en la Escuela Oficial Rural Mixta del cantón...
Desde hace más de tres años busca a su hijo
Por Carlos González | Juan Agustín Siquiná Cotoc, de 53 años, originario de Almolonga, Quetzaltenango, busca de manera desesperada a su hijo, Amílcar Moisés Siquiná Riscajche, de 27. Amílcar, según informó Juan Agustín, desapareció el 22 de enero de 2018, y desde...
Detenido por el robo de 40 baterías de vehículo
Por Redacción Sucesos | Este miércoles, en el kilómetro 88 de la ruta al Atlántico, en jurisdicción de la aldea La Virgen, San Cristóbal Acasaguastlán, El Progreso, fue capturado Esteban Loarca González, de 27 años. El arresto fue luego de una persecución que inició...
El Salvador: optimismo por anulación de acuerdo migratorio con EE.UU.
El gobierno salvadoreño reaccionó con optimismo a la decisión del presidente de Estados Unidos, Joe Biden, de suspender el Acuerdo de Cooperación de Asilo para migrantes “ACA”, que firmaron los países del Triángulo Norte centroamericano (Guatemala, Honduras y El...
Seúl aplica la distancia entre mascotas para evitar contagios de COVID-19
Por Redacción Sucesos | En la capital de Corea del Sur, Seúl, la distancia social no solo se aplica a las personas, sino también a sus mascotas, y la intención es evitar contagios de COVID-19. En caso de dar positivo, deben cumplir cuarentena. El gobierno de Seúl...
Condenado a 25 años en prisión por asesinar a su hermano y luego enterrar el cuerpo
Por Fredy de León | Con una tercera sentencia se cierra una historia que consternó al departamento de Sololá. Víctor Ben Morales, de 25 años, fue hallado culpable de ejecutar a su medio hermano, en el año 2017, y luego enterrar el cuerpo en un área boscosa del cantón...
Peatón muere arrollado en la zona 5 de Xela
Por Shirlie Rodríguez | Este miércoles, investigadores del Ministerio Público (MP) informaron que no identificaron al peatón, quien falleció el martes reciente por la noche, luego de ser arrollado. La tragedia vial se registró cerca del paso a desnivel de Las Rosas,...
PNC arresta a «El Cuco» durante operativo en la zona 7 de Guatemala
Por Redacción Sucesos | Agentes de la División Nacional Contra el Desarrollo Criminal de las Pandillas (Dipanda) de la Policía Nacional Civil (PNC) arrestan a Luis Alfredo Herrera López, de 33 años, alias «El Cuco». El arresto fue durante un operativo en la zona 7 de...
Incendio en fábrica de camas en Xela deja pérdidas por más de Q10 millones
Por Carlos González y Shirlie Rodríguez | Este miércoles en la madrugada, se registró un incendio en una fábrica de camas en el cantón Choquí, zona 6 de Quetzaltenango, ruta hacia la aldea San José Chiquilajá....